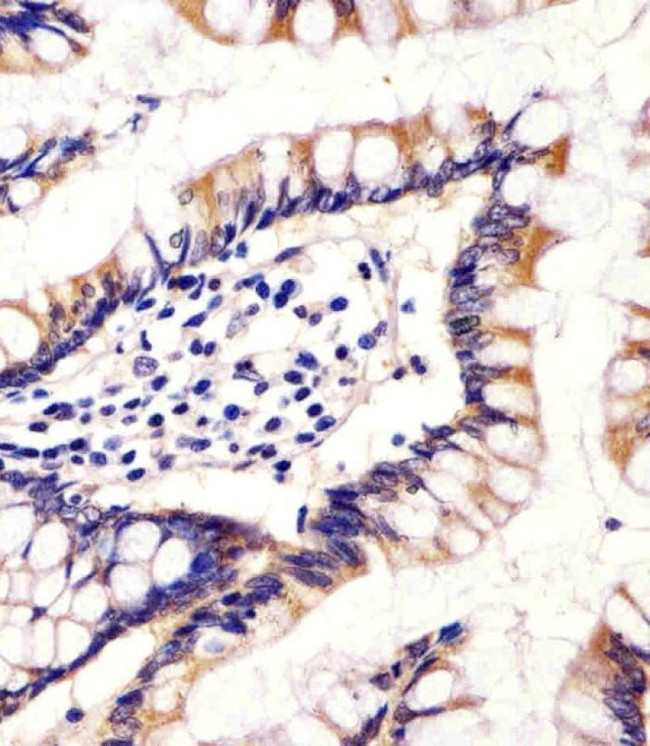
CYP11B2 Antibody in Immunohistochemistry (IHC)

Search
Invitrogen
CYP11B2 Polyclonal Antibody
{{$productOrderCtrl.translations['antibody.pdp.commerceCard.promotion.promotions']}}
{{$productOrderCtrl.translations['antibody.pdp.commerceCard.promotion.viewpromo']}}
{{$productOrderCtrl.translations['antibody.pdp.commerceCard.promotion.promocode']}}: {{promo.promoCode}} {{promo.promoTitle}} {{promo.promoDescription}}. {{$productOrderCtrl.translations['antibody.pdp.commerceCard.promotion.learnmore']}}
产品信息
PA5-71492
宿主/亚型
分类
类型
抗原
偶联物
形式
浓度
规格
保存条件
运输条件
RRID
靶标信息
This gene encodes a member of the cytochrome P450 superfamily of enzymes. The cytochrome P450 proteins are monooxygenases which catalyze many reactions involved in drug metabolism and synthesis of cholesterol, steroids and other lipids. This protein localizes to the mitochondrial inner membrane and is involved in the conversion of progesterone to cortisol in the adrenal cortex. Mutations in this gene cause congenital adrenal hyperplasia due to 11-beta-hydroxylase deficiency. Transcript variants encoding different isoforms have been noted for this gene.
仅用于科研。不用于诊断过程。未经明确授权不得转售。